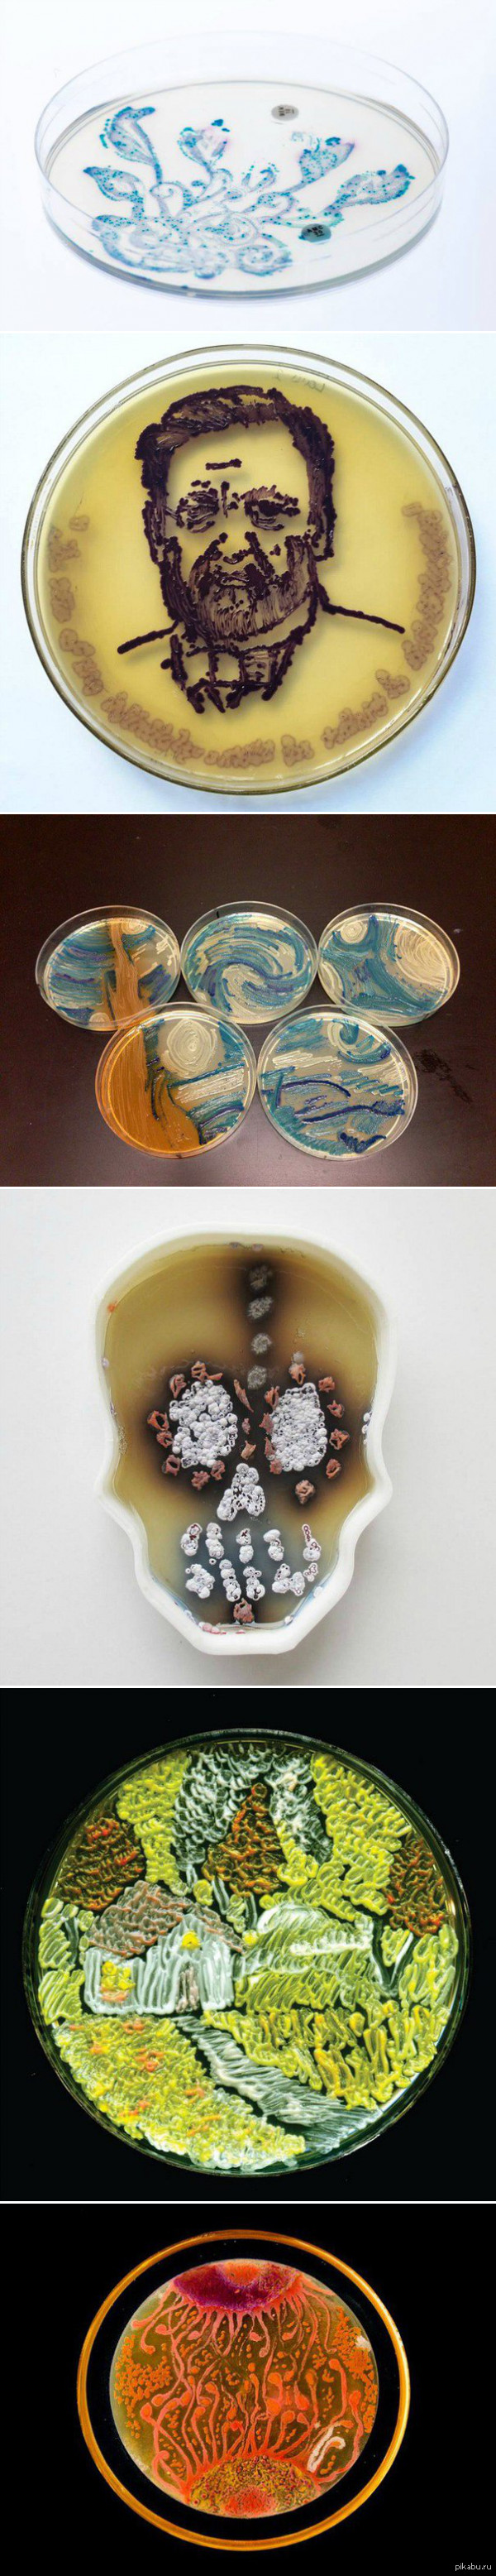

eskasa
11К
рейтинг
1 подписчик
19 подписок
32 поста
5 в горячем
Награды:
Какоксенит
Необычный камень какоксенит относится к классу водных фосфатов и является довольно редким минералом. В переводе с греческого языка какоксенит означает «плохой гость», такое название он получил из-за того, что в составе минерала присутствует фосфор и это снижает качество выплавляемого железа. В природе существует разных цветов: зеленый, коричневый, желтый, оранжевый и красный. Представляет собой игольчатые кристаллы. Является очень редким и ценным камнем, из которого изготавливают красивые и дорогие украшения.
Показать полностью
1
Спорить с преподавателем — себе дороже
У студентов есть поговорка «Спорить с преподавателем — себе дороже». Однажды один студент Оксфорда это наглядно подтвердил. В то время, когда проходила сдача экзамена, он потребовал кружку пива. Такова была древняя традиция этого знаменитого университета. Как ни странно, наглый студент получил то, что требовал и тут же был оштрафован преподавателем. Но абсолютно не за то, что позволил себе распивать спиртное. Сослался преподаватель на еще более древнюю традицию: обучающимся этого престижного вуза запрещено появляться на экзамен без шпаги.